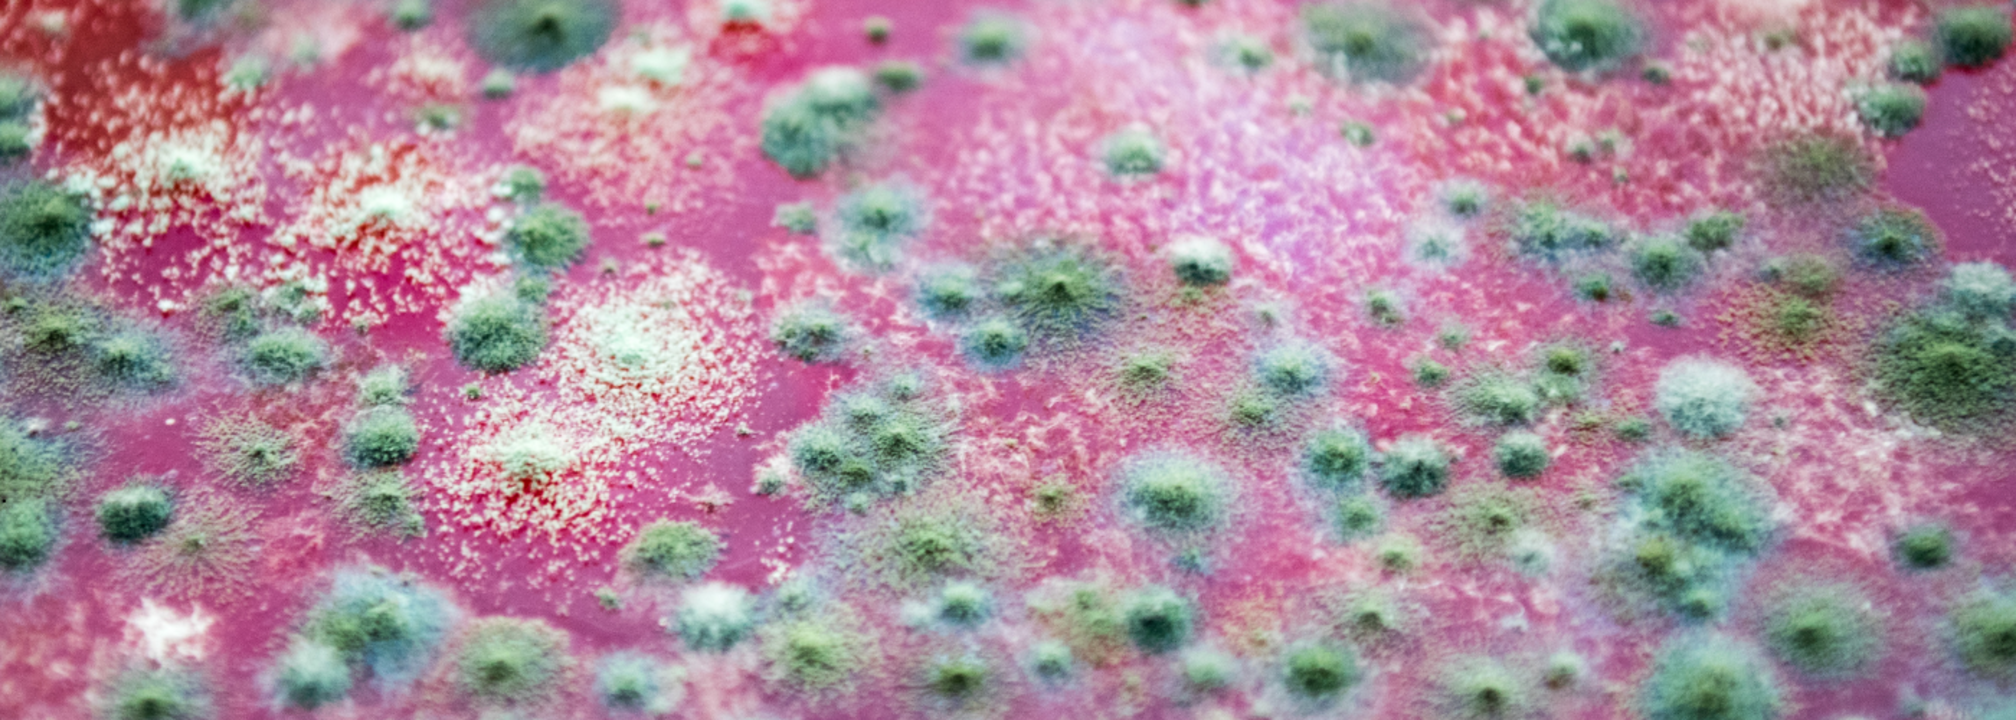

FDA Launches An Online Tool That Can Check Contaminant Levels In Foods
Credits: Canva
SummaryFDA's role is also to set tolerances, action levels and guidance levels of contaminants in food to protect public health. This means, it is widely accepted that food will be contaminated by the outside world, it will have other things mixed in it. However, the contaminants levels should match or be within the FDA guidelines for it to be safe for public and to ensure the safety of products marketed to US consumers.
End of Article
